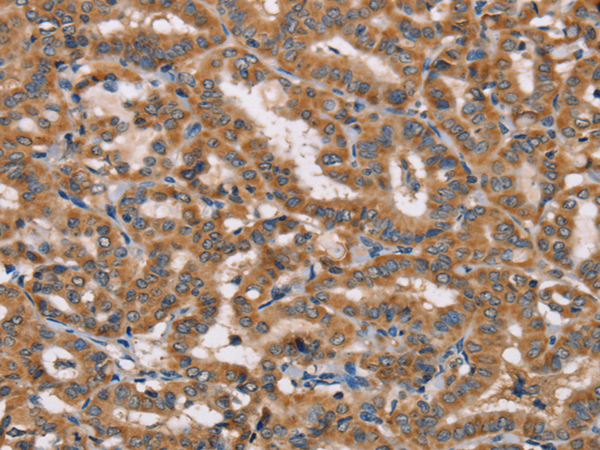
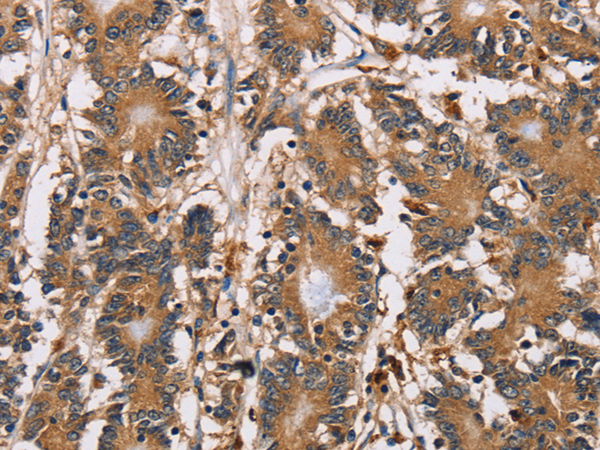
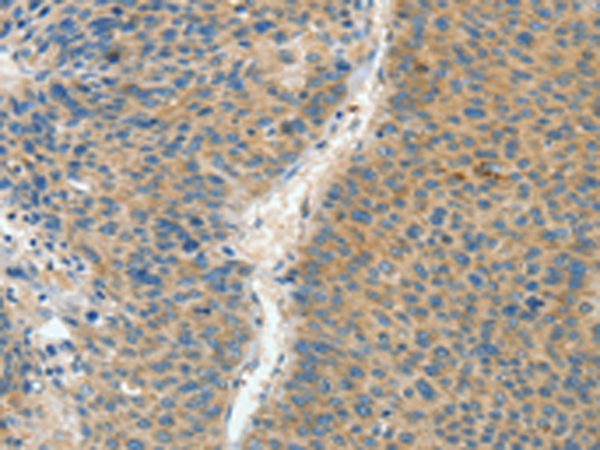
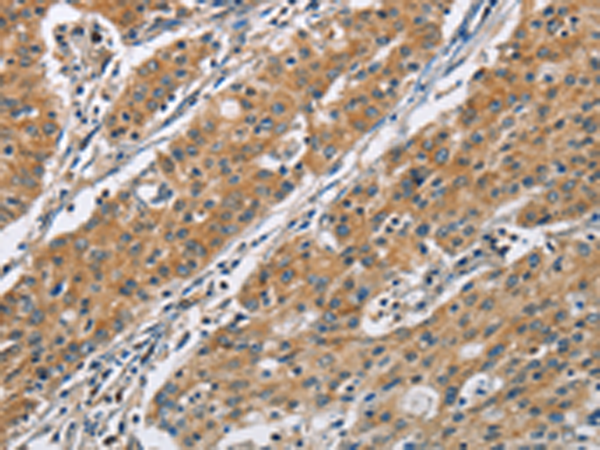

-
分类: 科研抗体货号: P08053别名: BBP; 53BP2; ASPP2; P53BP2; PPP1R13A应用: WB,IHC反应种属: Human, Mouse
-
分类: 科研抗体货号: P08036别名:应用: WB,IHC反应种属: Human
-
分类: 科研抗体货号: P08071别名:应用: WB反应种属: Human, Mouse, Rat
-
分类: 科研抗体货号: P08052别名: cCAT; GIG18; cAspAT; ASTQTL1应用: WB,IHC反应种属: Human, Mouse, Rat
-
分类: 科研抗体货号: P08035别名: TS11应用: WB,IHC反应种属: Human, Mouse, Rat
-
分类: 科研抗体货号: P08051别名: GLC1F应用: IHC反应种属: Human, Mouse
-
分类: 科研抗体货号: P08070别名: PGI; DSPG1; PG-S1; SLRR1A应用: WB,IHC反应种属: Human, Mouse, Rat
-
分类: 科研抗体货号: P08034别名: ASP; ACY2应用: WB,IHC反应种属: Human, Mouse, Rat
-
分类: 科研抗体货号: P08068别名: COPB应用: WB,IHC反应种属: Human, Mouse, Rat
-
分类: 科研抗体货号: P08050别名: ASB-3应用: WB反应种属: Human

鄂公网安备42018502007531号
鄂公网安备42018502007531号

